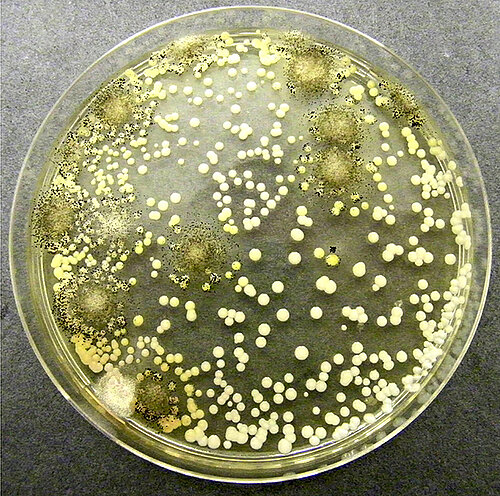

Food Products / Cosmetics / Consumer Goods
such as Animal feeds and Nutrional supplements
- Microbiological tests for Food stuff in accordance with ASU § 64 LFGB (German Food and Feed Code)
- Shelf life test for food and cosmetics (individual test planning)
- Challenge test for cosmetics in accordance with Ph.Eur 5.1.3
- Producing microorganism cultures for different applications
- Bacterial reverse mutation test (Salmonella mutagenicity test / AMES-Test) in accordance with OECD-Guideline 471
- Permeability test of packaging material in accordance with DIN 58953-6
- Consulting services for food and cosmetics production and food processing
for instance to comply with EU Ordinance 2073/2005
Private cross-check experts
licensed in the state of Berlin pursuant to § 46 Clause 1 No. 1 b LFGB for testing specimens officially left behind pursuant to § 43 LFBG for food and tobacco products, consumer goods and cosmetics. (Link to the list of LaGeSo)

Tested cosmetic products may be marked with the "Laborgeprüft" (Laboratory Tested) seal.
"Laborgeprüft" is an independent assurance mark designed to foster greater transparency and trust within the cosmetics market. The brand makes verifiable quality visible and serves as a symbol of reliable standards.
www.laborgeprueft.eu